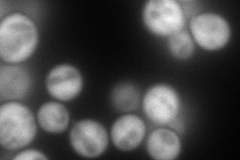
YLR377C
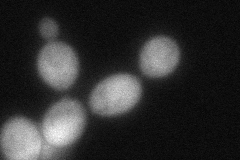
YLR377C
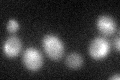
YLR377C

View description
Fructose-1,6-bisphosphatase, key regulatory enzyme in the gluconeogenesis pathway, required for glucose metabolism; undergoes either proteasome-mediated or autophagy-mediated degradation depending on growth conditions; interacts with Vid30p
Localization:
Intensity:
Fold change:
Significance:
-
C’ GFP library in SD

below threshold14.58 -
N' NOP1pr-GFP in SD
cytosol275.792 -
N' TEF2pr-mCherry in SD

cytosol424.274 -
N' NATIVEpr-GFP in SD

cytosol20.4302 -
N' TEF2pr-VC and Cyto-VN in SD
cytosol84.5452 -
C’ GFP library in SD+DTT
cytosol17.751.21No -
C’ GFP library in SD+H2O2

cytosol17.771.21No -
C’ GFP library in Starvation Media

cytosol24.061.64No -
C’ GFP library on the background of Pup2-DaMP

below threshold -
C’ GFP library on the background of CCT mutant

below threshold15.37971.05448No
